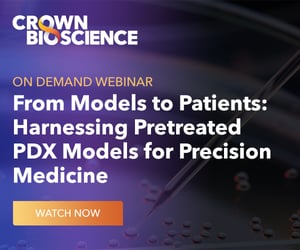

On Demand Webinar
From Models to Patients: Harnessing Pretreated PDX Models for Precision Medicine

The poor translatability of early-stage preclinical models is a major setback in oncology drug development, and inter patient tumor heterogeneity is also a significant hurdle. Pretreated PDX models, derived directly from tumors of patients who received known treatments before sample collection, have promising applications for precision medicine.
Participate in this Webinar to Learn About:
- The importance and value of Pretreated PDX models that reflect current clinical unmet needs.
- What to anticipate for future unmet needs in oncology.
- The establishment of pretreated PDX models with detailed treatment histories including KRAS inhibitors and checkpoint inhibitors.
Watch Now!
About the Presenters:
 Rekha Pal, PhD, Senior Director, Scientific Engagement, Crown Bioscience
Rekha Pal, PhD, Senior Director, Scientific Engagement, Crown Bioscience
Dr. Pal is a trained cancer biologist with a focus on preclinical cancer therapeutics, immune-oncology, cancer signaling, and tumor microenvironment. She earned her PhD in Biochemistry from Central Drug Research Institute, India.
She joined the University of Pittsburgh as a postdoctoral researcher and moved onto research faculty. She has extensively worked in stem cell biology and translational cancer research using patient’s blood, tumor and bone marrow samples with a correlation of clinical data for the targeted biomarker identification with the drug treatment.
She joined National Surgical Adjuvant Breast and Bowel project (NSABP), a clinical trial supportive group to develop strategies for preclinical evaluation of test agents to support NSABP’s phase I/II clinical trials for colon and breast cancer. She also led the effort of organoids generation from the PDX tumor tissue to screen drugs or drug combinations as personalized medicine. Rekha represented NSABP as a translational research committee member on B-50 Katherine-B027938 Roche study.
Dr. Pal’s role at Crown Bioscience is to direct scientific engagement with pharmaceutical companies, academic scientists, and clients. She helps indecision making with the goal of high scientific input in study design and model execution. She exchanges scientific information for existing and new opportunities between Business Development and the scientific team, generates protocols, study design and proposals to define projects/ studies.
 Anthony W. Tolcher, MD, FRCPS(C), FACP, FASCO, CEO and Founder, NEXT Oncology™
Anthony W. Tolcher, MD, FRCPS(C), FACP, FASCO, CEO and Founder, NEXT Oncology™
Dr. Tolcher is the CEO and Founder of NEXT Oncology™, a Phase I group that seeks to transform early clinical trials. NEXT Oncology’s mission is to accelerate the next breakthrough medicines for cancer. Our vision is to be the most successful and respected Phase I program in oncology research. The NEXT Oncology sites include San Antonio, Austin, Dallas, Fairfax, Virginia, Barcelona, and Madrid, Spain. Dr. Tolcher served as President and Co-Founder of START LLC from 2009- 2018, one of the world’s largest Clinical Phase I and early drug development operations in cancer medicine with 5 locations in San Antonio, Texas; Grand Rapids, Michigan; Madrid, Spain; and Shanghai China. Dr. Tolcher is a medical oncologist with over 25 years of experience in early drug development and clinical trials. He has been involved in many of the initial Phase I studies of new agents that subsequently were FDA approved for the treatment of cancer, including pembrolizumab (Keytruda), copanlisib (Aliqopa), trastuzumab emtansine (Kadcyla), regorafenib (Stivarga), liposomal vincristine (Marqibo), cabazitaxel (Jevtana), carfilzomib (Kyprolis), gefitinib (Iressa), erlotinib (Tarceva), and eribulin (Halaven). He is currently the principal investigator on 40 Phase I clinical studies and is a reviewer for the Journal of Clinical Oncology, Clinical Cancer Research, and Annals of Oncology. He has chaired the Developmental Therapeutics Review Committee for the American Association of Clinical Oncology Annual Scientific Program. Dr. Tolcher has over 100 peer-reviewed publications in scientific journals, including Nature, Proceedings of the National Academy of Sciences (USA), Journal of Clinical Oncology, and Clinical Cancer Research, and is the author of nine book chapters.

Rekha Pal, PhD, Senior Director, Scientific Engagement, Crown Bioscience
Rekha Pal, PhD, Senior Director, Scientific Engagement, Crown Bioscience Anthony W. Tolcher, MD, FRCPS(C), FACP, FASCO, CEO and Founder, NEXT Oncology™
Anthony W. Tolcher, MD, FRCPS(C), FACP, FASCO, CEO and Founder, NEXT Oncology™
